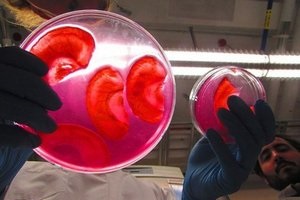

Sérülés, kezelés, okai, tünetei, megelőzése
- Mi egy zúzódás
- tünetei Bruised
- Bruised kezelés
- Melyik az orvosok a kapcsolatot, ha van egy horzsolás
Mi egy zúzódás
Contusio - egy zárt mechanikai sérülés a lágy szövetek és szervek anélkül, hogy nyilvánvaló megsértése azok anatómiai integritását. Általában van egy esés vagy ütés egy tompa eszköz, amelynek kicsi a mozgási energiát. A leggyakoribb külső (felületi) sérülések a fej és a végtagok.
tünetei Bruised
A sérülések kialakulása jellemez egy zúzódás, amely által okozott impregnálással a bőr és a bőr alatti szövet áramlott a vér. Előfordulásának ideje zúzódás vérzés függ mélységben. Ha a sérülés a bőr és a bőr alatti szövetek, azonnal megjelenik az első percben és órában. Ha sérülés izmok, csonthártya zúzódások jelenik meg a második vagy a harmadik napon, néha messze attól a helytől, a sérülés. Az advent a fejlett zúzódás, főleg távol a sérülés helyén egy komoly tünet, és további vizsgálatot igényel, mint az X-ray - kizárni törés vagy csonttörés. Színes zúzódás megy bizonyos változtatások miatt hemoglobin lebontása. Friss zúzódás piros után 5-6 nap múlva zöldre vált, majd sárga. A szín egy horzsolás látható alapszabály sérülés.
Bruised kezelés
Melyik az orvosok a kapcsolatot, ha van egy horzsolás
Promóciók és akciók
- Listája vezető orvosi ellátás
- Snow-fehér mosoly 24 perc alatt. Fogfehérítés lámpa «LUMA COOL»
- A gyümölcsök és zöldségek lehet „tan
- A betegségek listája A-tól Z-ig
orvosi hírek


A tudósok a University of North Carolina találtuk, hogy a immundeficiencia vírus lehet elhelyezni nem csak a vérsejtek (T-sejtek), hanem más szövetek a test. A szakértők megállapították, hogy a vírus lehet található az úgynevezett makrofágok (amoeboid sejtek).

Magyarországon az Egészségügyi Minisztérium jóváhagyta a gyógyszer Revoleyd (Eltrombopag) gyermekek számára. Az új gyógyszer javallt betegek szenvednek krónikus immunológiai trombocitopénia (idiopátiás trombocitopéniás purpura, ITP), egy ritka betegség a vér-rendszer.
Kanadai tudósok a University of Ottawa fog forradalmasítani regeneratív orvoslás. Az egyik utolsó kísérletek voltak képesek növekedni az emberi fül a szokásos alma.

A szakértők első Pavlov Orvosi Egyetemen létrehozott nanorészecskék, amellyel a lehető diagnózisát infarktus előtt infarktusos beteget. Szintén a hosszú távú vizsgálatok során, a nanorészecskék fogja használni.
orvosi cikkek
A vírusok nem csak lebeg a levegőben, hanem lehet kapni korlátok, ülések és egyéb felületek, miközben tevékenységük. Ezért, ha utazáskor vagy nyilvános helyen, kívánatos nemcsak, hogy megszüntesse a kommunikáció másokkal, hanem hogy ne.
Kozmetikai készítmények, amelyek célja, hogy vigyázzon a bőr és a haj, sőt, lehet, hogy nem olyan biztonságos, mint azt gondoljuk,
Lactostasis - által okozott állapot késéssel anyatej a mirigyben és a csöveit. A változó súlyosságú lactostasis fordul minden nő szülés után, különösen, ha a szállítás volt az első.